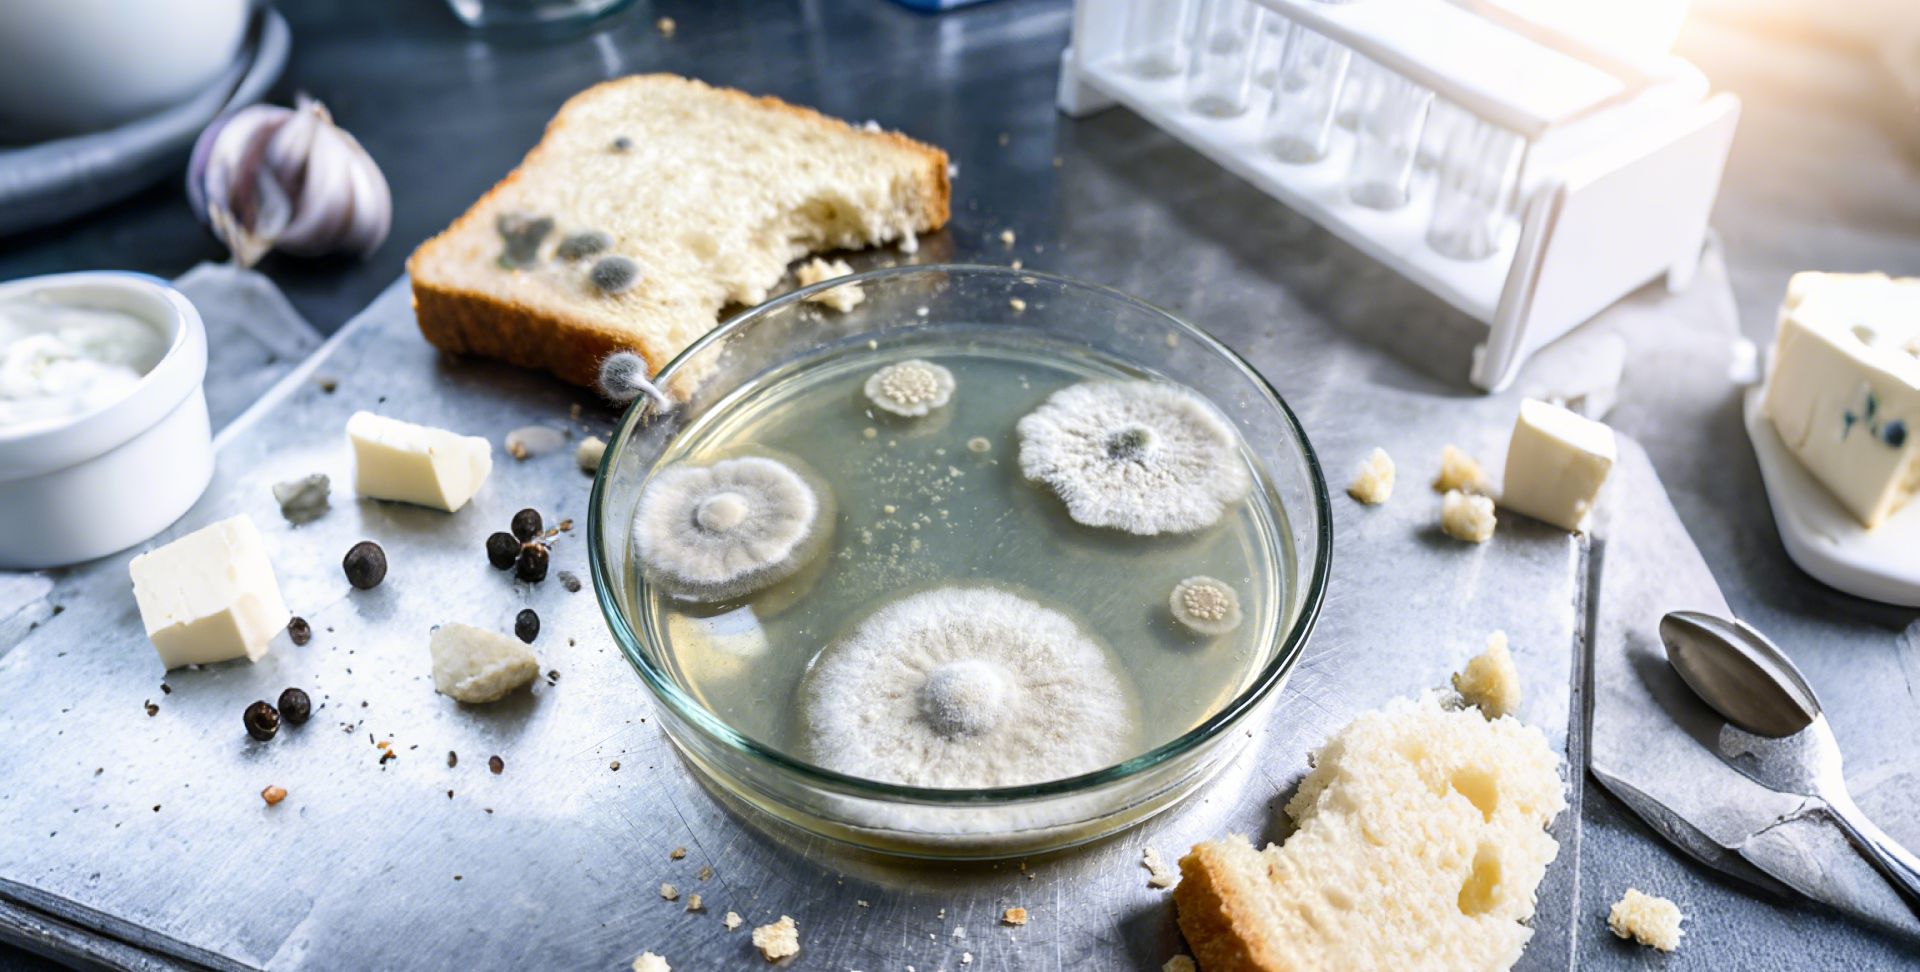

实验室是科研探索的核心阵地,承载着化学试剂、精密仪器、生物样本等各类高风险实验资源,每一项操作都容不得半点马虎。“禁止携带食物、饮品进入实验室,严禁在实验室内饮食、喝水”,是实验室安全规范中最基础却也最易被轻视的一条铁律。很多人觉得 “喝口水、吃块点心” 是小事,殊不知这看似无害的行为,背后藏着对生命健康、实验成果与实验室安全的多重致命威胁。今天,我们就来拆解这条禁令背后的深层逻辑,读懂每一条规定的硬核必要性。

实验室的环境特殊性,决定了食物、饮品的存在本身就是移动的安全隐患,其危害远超日常认知,主要集中在人身健康、实验准确性、安全事故三个核心维度。
(一)化学污染无孔不入,误食即伤健康实验室中充斥着各类化学试剂 —— 强酸强碱、有机溶剂、有毒挥发物、腐蚀性物质,它们可能以溅出、挥发、渗透等多种方式污染周边环境。裸露的食物、未密封的饮料,无异于 “污染接收器”,极易吸附这些有害物质,且很多污染肉眼根本无法察觉。
比如,甲醇、苯等挥发性有机溶剂会渗入未盖紧的饮料中,误食后会直接损伤消化道与神经系统,严重时可致昏迷;浓硫酸、氢氧化钠等腐蚀性试剂若溅到食物上,食用后会灼伤口腔、食道,造成不可逆的器官损伤;氰化物、砷化物等剧毒试剂,哪怕只有微量混入食物,长期摄入也会累积中毒,损害肝、肾等核心脏器。更隐蔽的是,一些无色无味的试剂污染,会在不知不觉中慢慢侵蚀人体,等出现症状时往往已追悔莫及。
(二)实验洁净被破坏,科研成果全白费科学实验对样品纯度、洁净度的要求近乎严苛,一丝外来杂质都可能让整个实验功亏一篑。食物与饮品中含有的微生物、油脂、有机物等,一旦进入实验体系,会直接污染实验样本,导致实验数据失真、结果无效,浪费大量的时间、人力与科研资源。
在生物实验室中,面包屑、饮料残留携带的细菌、真菌,会让细胞培养皿、培养基彻底污染,细胞培养直接失败;在化学实验中,食物中的有机物会与试剂发生副反应,干扰实验进程,得出错误结论;即便是精密仪器实验室,掉落的食物碎屑、洒出的饮料也会堵塞仪器管路、腐蚀精密部件,降低仪器精度,缩短使用寿命,让昂贵的设备陷入瘫痪。
(三)安全隐患层层叠加,意外事故一触即发食物与饮品的存在,会大幅增加实验室火灾、爆炸、触电等意外事故的发生概率,堪称 “定时炸弹”。
实验室中大量易燃试剂(如乙醇、乙醚)遇明火极易引发火灾,而含糖、油脂的零食,以及酒精类饮品本身就具有可燃性,一旦接触明火、高温仪器或试剂溅洒,瞬间就可能酿成火灾;饮品洒落在实验台或仪器上,会导致线路短路、仪器损坏,甚至引发触电事故;食物碎屑还会吸引老鼠、蟑螂等害虫,这些害虫会咬坏实验线路、啃食实验样本,进一步破坏实验室的安全与洁净环境。
二、实验中禁饮禁食:别让分心与污染酿成大祸即便没有提前携带食物饮品,实验过程中饮食、喝水也被严格禁止,这并非不近人情,而是为了规避操作中的隐形风险,守住实验安全的最后一道防线。
(一)试剂误食风险陡增,操作分心易酿祸实验过程中,实验人员的手部、衣物即便佩戴了手套,也可能出现手套破损、试剂渗透的情况。此时饮食、喝水,手上残留的试剂会通过食物、水杯传递到口腔,引发误食中毒、灼伤等伤害。
更危险的是,实验室中不少试剂的外观、气味与日常饮品高度相似 —— 无色透明的蒸馏水、酒精溶液,很容易在实验分心时被误饮。而一旦误食有毒试剂,轻则送医急救,重则危及生命。同时,饮食、喝水会打断实验操作的连贯性,分散注意力,极易导致操作失误,比如试剂加错、仪器操作不当,进而引发连锁反应的安全事故。
(二)打破实验秩序,破坏实验室洁净环境实验室内的核心任务是专注操作,饮食、喝水属于与实验无关的行为,会打破实验室的规范秩序,滋生侥幸心理。一边操作试剂一边喝水,可能因手忙脚乱导致试剂溅洒;随手将水杯、零食放在实验台,可能碰倒试剂瓶、撞翻精密仪器,引发危险。
同时,饮食过程中产生的食物碎屑、饮料残留、飞沫,会直接污染实验台、仪器与样本,破坏实验室的洁净环境。尤其是无菌实验室、精密仪器实验室,对环境洁净度要求极高,一次饮食行为就可能让整个实验室的洁净标准付诸东流。
三、结语:敬畏规则,守住实验室安全底线
实验室的每一条安全禁令,都不是凭空制定的条条框框,而是无数实验事故的血泪总结,其核心目的只有一个 ——保护实验人员的生命健康,保障科研实验的顺利开展,维护实验室的安全与秩序。
禁止携带食物饮品、禁止实验中饮食喝水,看似是 “小题大做”,实则是防范安全风险的关键一步。作为科研人员、实验学习者,我们必须摒弃侥幸心理,真正将安全意识刻在心里、落实在行动上:自觉不携带食物饮品进入实验室,实验全程不饮食、不喝水,结束后及时清洁双手与实验台。
实验室安全无小事,每一条规则都值得敬畏,每一次遵守规范都是对自己、对他人、对科研事业的负责。让我们共同守护安全的实验环境,让科学探索在安全的基石上稳步前行。